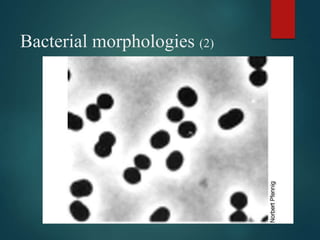
Bacterial morphologies (2)

This document discusses the history and key discoveries related to the study of bacterial cell structure and morphology. It outlines important findings by Hooke, van Leeuwenhoek, Brown, Schleiden & Schwann that helped establish the cell theory. The document then describes the distinguishing features of prokaryotic and eukaryotic cells. Finally, it provides detailed information on bacterial cell structures including cell walls, membranes, flagella, pili, and endospores.






![Cell Theory Overview
1. All organisms are made of one or more cells
[Unicellular or Multicellular].
2. All cells carry on life activities.
3. New cells arise only from other living cells.](https://image.slidesharecdn.com/lecture2-bacterialcellstructureandfunction1-230511133131-af02c249/85/Bacterial-Cell-structure-and-Function-1-ppt-7-320.jpg)